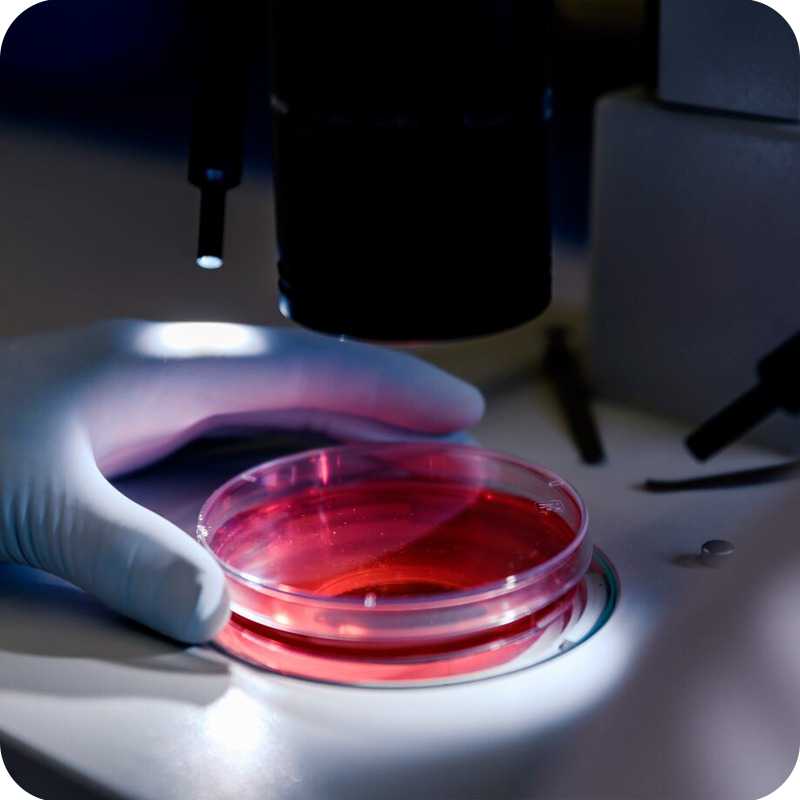
imagen análisis bioquímicos

Herramientas de accesibilidad
Todos los servicios que ofrecemos
Análisis Bioquímicos
Mide tus niveles de colesterol, triglicéridos o glucosa en la farmacia. Una sencilla prueba para un mejor control de tu salud cardiovascular.

Cosmética Personalizada
Realizamos un estudio de tu piel con Dermoprime para darte el mejor asesoramiento y la recomendación de cosmética más adecuada.

Fitoterapia y Natural
Somos especialistas en indicación farmacéutica con productos de origen natural. Consúltanos para cuidar tu salud de forma complementaria.

Formulación Magistral
En nuestro laboratorio, preparamos de forma individualizada aquellos medicamentos o dosis que necesites. Confía en la calidad de nuestra formulación magistral.

Nutrición y Dietética
Ponte en manos de nuestro nutricionista para alcanzar tus objetivos de peso y salud. Pide tu cita, ¡te ayudaremos con un plan adaptado!

Ortopedia
Tenemos una gran variedad de ayudas para la movilidad y órtesis especializadas. ¡Te ayudamos a encontrar el producto de ortopedia perfecto, incluso con prescripción!

SPD Medicamentos
Te facilitamos la toma de tu medicación semanal o mensual. Con el sistema SPD de dosificación, nunca olvidarás ni confundirás tus dosis.

Toma de Tensión
Controlar tu presión arterial es clave para prevenir riesgos cardíacos. Acércate a la farmacia, ¡te la tomamos de forma rápida y gratuita!

Dermoanálisis de cuero cabelludo y cabello con IMD
Evaluamos el estado de tu cuero cabelludo y cabello con el método IMD. Te damos consejos y productos personalizados para un cuidado más efectivo.

Cuidado infantil
Tenemos todo lo que necesitas para el cuidado y el bienestar de tu bebé. Ven a la farmacia y te aconsejaremos con fiabilidad en cada etapa.


Reserva tu cita en Farmacia Casaudoumeq CB
Para más información sobre nuestros servicios o para reservar una cita, no dude en ponerse en contacto con nosotros o visitar nuestra farmacia.

